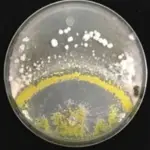

BEDNAR презентував оновлену важку дискову борону ATLAS AO_PROFI GEN II
04.10.2025
Виявлено гриб, який виділяє леткі органічні сполуки, що пригнічують ріст патогенів сільськогосподарських культур
04.10.2025Україна спостерігає значне зменшення обсягів імпорту мороженої риби, що свідчить про певні зміни на вітчизняному продовольчому ринку. За даними аналізу зовнішньоекономічної діяльності, у період з січня по серпень 2025 року країна придбала за кордоном 119,8 тис. тонн мороженої риби, виключаючи рибне філе. Цей показник є на 13,4% меншим порівняно з аналогічним періодом попереднього 2024 року. Таке скорочення імпорту мороженої риби може мати багатогранний вплив як на вітчизняних споживачів, так і на ринок загалом.
Читай нас також у Viber та Telegram.
Якщо розглядати ситуацію у грошовому еквіваленті, то обсяг коштів, витрачених на імпорт мороженої риби, також зменшився. Згідно з останньою статистикою, він скоротився на 2,5%, досягнувши відмітки у $253,5 млн за січень-серпень 2025 року порівняно з аналогічним періодом 2024 року. Така динаміка свідчить не лише про кількісні, але й про цінові зміни на світовому ринку, або про переорієнтацію українського ринку на дешевші види продукції, що впливає на загальний обсяг торгівлі рибою.
Серед найбільших постачальників мороженої риби в Україну протягом зазначеного періоду 2025 року виділяються три ключові країни. Лідерство утримує Ісландія, частка якої склала 17,4% від загального обсягу імпорту. За нею йде Норвегія з 13,4%, а третю позицію посідають Сполучені Штати Америки з часткою у 11,6%. Ці дані підкреслюють сталість співпраці з традиційними партнерами, проте також можуть вказувати на пошук нових ринків або зміни у вимогах до поставок.
Зменшення імпорту мороженої риби в Україну може бути обумовлене різними факторами. Серед них — коливання курсу національної валюти, що робить імпортні товари дорожчими для кінцевого споживача. Також не виключено зростання внутрішнього виробництва рибної продукції або переорієнтація населення на інші види білкової їжі. Зміни в купівельній спроможності населення також відіграють значну роль, впливаючи на попит на дорогі імпортні продукти.
Для українських агропідприємств, таких як Агрофірма П’ятихатська, яка виробляє органічну пшеницю, ячмінь, кукурудзу, соняшник, ріпак та гречку, розуміння таких тенденцій на продовольчому ринку є важливим. Хоча їхня продукція не пов’язана безпосередньо з рибою, загальна економіка України та динаміка імпорту є ключовими індикаторами для планування виробництва та збуту. Зміни в одному секторі харчової промисловості часто мають ефект доміно на інші. Наприклад, якщо попит на рибу зменшується, споживачі можуть звертати увагу на інші джерела білка, такі як м’ясо або рослинні білки, що може вплинути на попит на зернові культури для кормів або виробництва альтернативних продуктів харчування. Для глибшого розуміння макроекономічних показників та їх впливу на різні галузі, варто звернутися до аналітичних матеріалів на pravdoruv.live.
Підсумовуючи, скорочення імпорту мороженої риби в Україну є важливим сигналом для ринку. Воно відображає комплексні процеси, що відбуваються в економіці країни та можуть бути пов’язані як з внутрішніми змінами, так і з глобальними тенденціями. Відстеження цих показників дозволяє краще прогнозувати розвиток продовольчого ринку та адаптувати бізнес-стратегії до нових реалій, забезпечуючи стабільність та розвиток агропромислового комплексу. Ця тенденція може спонукати до подальших досліджень щодо причин та довгострокових наслідків для всієї харчової галузі України, включаючи сільськогосподарське виробництво.




